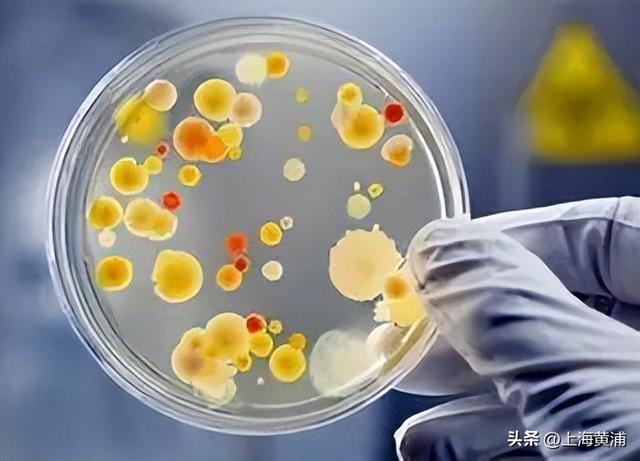

最近,不少市民逐渐康复,但由于喉咙不适,伴有咳嗽,不少人习惯性的摘下口罩随地吐痰。咳嗽咳痰,平时看似小细节,可关系到大健康,特别是在新冠病毒肆虐的日子,“小小一口痰、细菌千千万”,咳嗽咳痰吐痰,还要讲究个礼仪。
这些天,医院、公园、街头时不时能听到阵阵咳嗽声。1月9日上午,不到半小时,记者就看见四五个没戴口罩的市民,在咳嗽之后,随口将一口痰吐在了地上。
“老先生,刚刚你在随地吐痰吗?
“不用你管,我现在还阳着,你快走开。”
专家介绍,患感冒、流感、肺结核、肺炎等疾病的患者,会通过痰液把致病菌带出体外。有痰不吐也对健康不利 ,建议外出时随身携带纸巾,将痰吐到纸巾里,再丢入垃圾桶。按照《上海市民健康公约》“八不十提倡”明确“不随地吐痰”“咳嗽喷嚏遮口鼻”,将防控新冠疫情成果转化为市民健康理念和生活方式。
目前,已经证明痰液中含有的致病菌主要是可以引起呼吸道感染的细菌,包括肺炎链球菌、金黄色葡萄球菌、螺旋体等,也有可能可以检查出引起肺部寄生虫病的虫卵、幼虫等。

半淞园路街道社区卫生服务中心门诊办公室主任曹晓颖表示,“不要小看一口痰,里面细菌非常多,有许多细菌病毒真菌,跟着你吐痰时,飞沫喷出来, 随后在空气中存活,假使你在新冠感染期间,还可能引起传播的。”

曹晓颖介绍,咳嗽咳痰时,为了避免唾液飞溅,也避免污染双手。市民不妨随身携带“三样宝”,口罩、纸巾和保鲜袋。纸巾和保鲜袋处理痰积,带上备用口罩,以防口罩被飞沫或痰液污染时,能及时更换。咳嗽或打喷嚏时,尽可能避开他人;无法避开时,应背朝他人,用纸巾或弯曲的手肘尽量贴近脸部遮住口鼻,防止飞沫四溅。最后注意,咳嗽、吐痰或打喷嚏后,及时清洗双手或使用免洗手消毒剂。如果衣服被痰液污染,也要及时更换清洗。